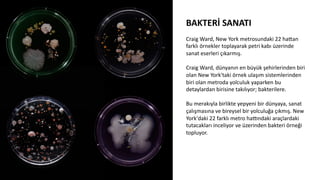
BAKTERİ	
  SANATI	
  
	
  
Craig	
  Ward,	
  New	
  York	
  metrosundaki	
  22	
  hadan	
  
farklı	
  örnekler	
  toplayarak	
  petri	
  kabı	
  üzerinde	
  
sanat	
  eserleri	
  çıkarmış.	
  
	
  
Craig	
  Ward,	
  dünyanın	
  en	
  büyük	
  şehirlerinden	
  biri	
  
olan	
  New	
  York'taki	
  örnek	
  ulaşım	
  sistemlerinden	
  
biri	
  olan	
  metroda	
  yolculuk	
  yaparken	
  bu	
  
detaylardan	
  birisine	
  takılıyor;	
  bakterilere.	
  	
  
	
  
Bu	
  merakıyla	
  birlikte	
  yepyeni	
  bir	
  dünyaya,	
  sanat	
  
çalışmasına	
  ve	
  bireysel	
  bir	
  yolculuğa	
  çıkmış.	
  New	
  
York'daki	
  22	
  farklı	
  metro	
  hapndaki	
  araçlardaki	
  
tutacakları	
  inceliyor	
  ve	
  üzerinden	
  bakteri	
  örneği	
  
topluyor.

Merhaba,
Kasım ayı yaprak dökümünün kışa merhaba diyen ayıdır,
pastırma yazı bu sene lodosla birleşince kışın ilk ayını farketmeden geçirdik nerdeyse. Biliyorsunuz Manifesto İletişim Grubu Trend Raporu’muzu her ay sizlerle paylaşıyoruz. Amacımız sizi yaşanan yeniliklerden ve ilginç kampanya öykülerinden haberdar etmek… Yeni sayımızda yine birbirinden farklı haberleri araştırdık. Markaların birbirinden özel kampanyaları yine doludizgin devam ediyor, önemli sanat etkinlikleri mekanları dolduruyor. Sanatın ve sanatçının her zaman yanında olan sanat platformumuz Magnum Opus’un sanat buluşmalarını ve yepyeni keşiflerinden derlediğimiz sanat dünyasından haberleri de yeni sayımızda keyifle okumanız dileğiyle…
Sevgiler,
Selin Bozkurt
Chief Energy Officer
Manifesto